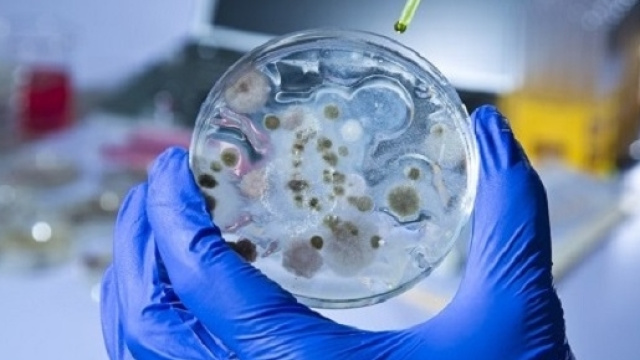
Scoperto batterio resistente agli antibiotici

L'uso di antibiotici nella nostra era è abbastanza frequente, fortunatamente da quando è stata scoperta la penicillina moltissime persone si sono salvate. Il tasso di mortalità prima dell'invenzione degli antibiotici era nettamente più alto a qualsiasi età, si poteva morire anche per molto poco: bastava una semplice malattia batterica. Ora però l'incubo sembra tornare.
Batterio Mcr 1, resistente agli antibiotici
Questo batterio contiene un gene che si sta diffondendo a macchia d'olio sulla terra, anche se è stato scoperto in tempi molto recenti, appena 18 mesi fa.
Un gruppo di scienziati che hanno partecipato al congresso 'American Society for Microbiology' ha lanciato un allarme decisamente inquietante per ogni sistema sanitario nazionale al mondo: un batterio con un gene chiamato Mcr-1 si sta diffondendo nel mondo, il problema è che non esiste ancora nessun antibiotico in grado di sconfiggerlo. Al momento è stato individuato principalmente in Cina ma anche in America e in altri Paesi. Il batterio è risultato resistente alla Colistina, l'antibiotico più potente finora messo a punto contro le minacce batteriche in quanto i normali antibiotici avevano fallito già da tempo. Non si tratta di un batterio killer che uccide sicuramente ma potrebbe indebolire il sistema immunitario tanto da portare il portatore a non riuscire a debellare semplici virus o altri batteri.
Questo potrebbe far diventare rischiose per la vita anche operazioni chirurgiche di routine o banali infezioni, come una semplice appendicite. Il quotidiano La Stampa addirittura sostiene che questo batterio potrebbe farci tornare indietro, come negli '20, quando si poteva morire per un'influenza o per una semplice ferita non disinfettata. Uno scenario non rassicurante, tanto che l'ONU, Regno Unito e associazioni mediche stanno sollecitando le case farmaceutiche ad accelerare la ricerca per trovare un rimedio.
L'abuso di antibiotici è la causa
L'uso massiccio e sconsiderato di antibiotici è la causa della nascita di batteri sempre più resistenti. Ed eccoci qui, si è avverato quello che temevamo, è nato il primo batterio resistente ad ogni cura finora esistente.
La Colistina, un antibiotico usato solo in circostanze di antibiotico-resistenza è risultato inefficace contro l'Mcr-1. Un antibiotico non largamente utilizzato perché ha degli effetti pesanti sui reni ma efficace nel debellare super batteri, ma purtroppo con questo nuovo gene non ci è riuscito. Speriamo che presto si arrivi ad una soluzione o veramente potremmo tornare in dietro di cento anni.